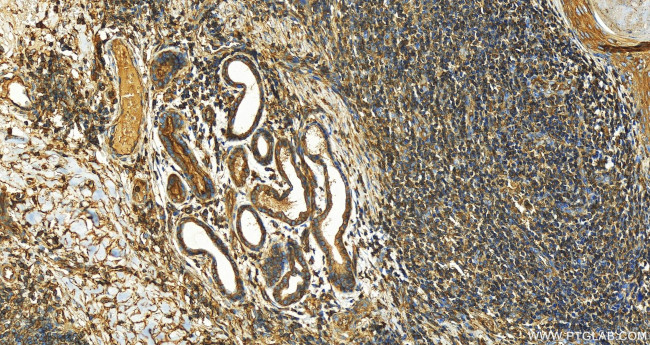
IQGAP1 Antibody in Immunohistochemistry (Paraffin) (IHC (P))

Search
Proteintech
IQGAP1 Monoclonal Antibody (2E11A2)
{{$productOrderCtrl.translations['antibody.pdp.commerceCard.promotion.promotions']}}
{{$productOrderCtrl.translations['antibody.pdp.commerceCard.promotion.viewpromo']}}
{{$productOrderCtrl.translations['antibody.pdp.commerceCard.promotion.promocode']}}: {{promo.promoCode}} {{promo.promoTitle}} {{promo.promoDescription}}. {{$productOrderCtrl.translations['antibody.pdp.commerceCard.promotion.learnmore']}}
产品信息
68588-1-IG
种属反应
宿主/亚型
分类
类型
克隆号
抗原
偶联物
形式
浓度
纯化类型
保存液
内含物
保存条件
运输条件
产品详细信息
Immunogen sequence: QLSSSVTGLT NIEEENCQRY LDELMKLKAQ AHAENNEFIT WNDIQACVDH VNLVVQEEHE RILAIGLINE ALDEGDAQKT LQALQIPAAK LEGVLAEVAQ HYQDTLIRAK REKAQEIQDE SAVLWLDEIQ GGIWQSNKDT QEAQKFALGI FAINEAVESG DVGKTLSALR SPDVGLYGVI PECGETYHSD LAEAKKKKLA VGDNNSKWVK HWVKGGYYYY HNLETQEGGW DEPPNFVQNS MQLSREEIQS SISGVTAAYN REQLWLANEG LITRLQARCR GYLVRQEFRS RMNFLKKQIP AITCIQSQWR GYKQKKAYQD RLAYLRSHKD EVVKIQSLAR MHQARKRYRD
靶标信息
This gene encodes a member of the IQGAP family. The protein contains four IQ domains, one calponin homology domain, one Ras-GAP domain and one WW domain. It interacts with components of the cytoskeleton, with cell adhesion molecules, and with several signaling molecules to regulate cell morphology and motility. Expression of the protein is upregulated by gene amplification in two gastric cancer cell lines.
仅用于科研。不用于诊断过程。未经明确授权不得转售。
篇参考文献 (0)
生物信息学
蛋白别名: DISP2; DISPB; p195; Ras GTPase-activating-like protein IQGAP1; RasGAP-like with IQ motifs
基因别名: HUMORFA01; IQGAP1; KIAA0051; p195; SAR1
UniProt ID: (Human) P46940
Entrez Gene ID: (Human) 8826, (Rat) 361598